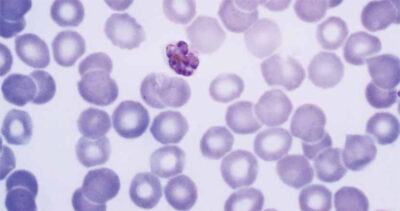
Photo: Dr. Mae Melvin, The Centers for Disease Control and Prevention Plasmodium malariae

2 billion
Modern health care is unthinkable without the availability of necessary medicines. Yet, close to 1 in 3 global citizens – 2 billion people globally – do not have access to lifesaving and health-supporting medicines. This directly challenges the fundamental principle of health as a human right. The theme of the NVTG annual symposium on October 16th 2015 addresses this injustice and places essential medicines in the middle of the debate on achieving Universal Health Coverage. In parallel to the symposium theme, this edition of MTb looks at essential medicines...
2 billion
Modern health care is unthinkable without the availability of necessary medicines. Yet, close to 1 in 3 global citizens – 2 billion people globally – do not have access to lifesaving and health-supporting medicines. This directly challenges the fundamental principle of health as a human right. The theme of the NVTG annual symposium on October 16th 2015 addresses this injustice and places essential medicines in the middle of the debate on achieving Universal Health Coverage. In parallel to the symposium theme, this edition of MTb looks at essential medicines from access, quality and rational use perspectives Rewriting the rules is needed, as according to ‘t Hoen the current pharmaceutical system can’t be justified because we fail to provide affordable medicines for the people and the communities that need them. Access to high priced medicine – currently a subject of fierce debate in the Netherlands (1) – is not only an issue for developed countries as seen in the assessment of Devalière et al., who compared prices of treatment for hepatitis C across Europe. Reforms of the research and development model and greater transparency may eventually avoid situations like the ones she found in Latvia. The problem also exists for other diseases and other low- and middle-income countries, as Ewen reports on poor insulin availability. Both Ravinetto and Dorlo address the devastating effects of medicines that do not comply with quality specifications (substandards) and of products that are intentionally and fraudulently produced (falsified medicines). Where Ravinette explores ethical challenges from a public health perspective, Dorlo looks at the role of the poor quality of antimalarials in the emergence and spread of resistance against antimalarials. Diseases that could easily be treated with antibiotics can become life-threatening again. In a post-antibiotics era, people would die of common infections. No, this is not science fiction. Rational use and prescription (focusing on the drivers of overuse, underuse or misuse of medicines) is the plea of Schippers, the Dutch Minister of Health, Welfare and Sports. It is expected that the Dutch government, during its EU presidency in 2016, will place antimicrobial/antibiotics resistance high on the political agenda. The first model list of essential medicines was published in 1977. However, it took some years to come up with action plans to improve access to and use of medicines. The plans from decades ago are still relevant today according to Hans Hogerzeil, professor Global Health and chair of the Lancet Commission on Essential Medicines Policies. Still, the proportion of the population without access to a basic range of affordable essential medicines of assured quality is large – very large – as if decades have passed without any progress. Of course that is not completely the case. Let positive examples guide us. It was not free-market forces which led to a 99% (!) decrease in the price of antiretroviral medicines. It was concerted international action that made this possible. Let’s consider this an example of how to deal with the long list of (new) essential medicines waiting to become affordable for those in need of treatment.
Esther Jurgens
Joost Commandeur